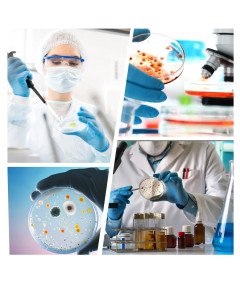
Szalki Petriego Laboratoryjne z Pokrywką Wentylowane 90 x 15 mm 10 szt

- -10%
Szalki Petriego Laboratoryjne z Pokrywką Wentylowane 90 x 15 mm 10 szt
Szybka wysyłka w: 24 godziny
od 10,99 zł (~2,80 €) – ORLEN Paczka
Darmowa dostawa: od 100 zł (~21,8 €)
Szalki Petriego Laboratoryjne z Pokrywką Wentylowane 90 x 15 mm 10 szt
Opis Produktu:
Zestaw 10 sztuk laboratoryjnych szalek Petriego o średnicy 90 mm i głębokości 15 mm to niezawodne narzędzie do hodowli mikroorganizmów w warunkach laboratoryjnych. Każda szalka wyposażona jest w przezroczystą pokrywkę z otworami wentylacyjnymi, które zapewniają lepszą cyrkulację powietrza i ograniczają kondensację. Wykonane z trwałego tworzywa sztucznego, idealne do zastosowań w biologii, mikrobiologii, medycynie i edukacji. Szalki nie są przystosowane do sterylizacji w wysokich temperaturach ani autoklawowania. Należy unikać kontaktu produktu z gorącymi płynami, które mogą spowodować odkształcenie plastiku.


Specyfikacja:
- Marka: Vabiooth
- Materiał: Plastik
- Wymiary: 90 x 15 mm
- Kolor: Przezroczysty
- Zastosowanie: Laboratoria, Szkoły, Uczelnie, Badania Biologiczne i Mikrobiologiczne
- Ilość: 10 szt
Cechy Produktu:
- Pokrywka wentylowana – Ogranicza kondensację i poprawia warunki hodowli
- Przezroczyste ścianki – Łatwa obserwacja próbek
- Solidna konstrukcja – Odporna na pęknięcia i odkształcenia
- Uniwersalne zastosowanie – Bakterie, grzyby, drożdże, pleśnie
- Gotowe do użycia – Idealne do eksperymentów i nauki


Podsumowanie: Szalki Petriego 90 × 15 mm z wentylowaną pokrywką to praktyczne i trwałe rozwiązanie do profesjonalnych i edukacyjnych zastosowań laboratoryjnych. Doskonałe do hodowli mikroorganizmów i prowadzenia eksperymentów w kontrolowanych warunkach.
8 innych produktów:
-
Elegancki Czarne Bikini SHEKINI z Regulowanym Topem, Rozmiar M
32,99 zł -10%29,69 złNajniższa cena tego produktu w ciągu ostatnich 30 dni przed obniżką wynosiła 29,03 zł brutto -
TONLEA Regały na wino Różowe złoto 2 sztuki 6cm x 23,5cm x 14cm
21,99 zł -10%19,79 złNajniższa cena tego produktu w ciągu ostatnich 30 dni przed obniżką wynosiła 19,35 zł brutto -
Etui do iPad Pro 11/Air 5/4 z Podstawką i Paskiem na Ramię Różowe
89,99 zł -10%80,99 złNajniższa cena tego produktu w ciągu ostatnich 30 dni przed obniżką wynosiła 79,19 zł brutto -
Szczotka do Włosów Cienkich Splątanych Zniszczonych Mokrych Srebrna
39,99 zł -10%35,99 złNajniższa cena tego produktu w ciągu ostatnich 30 dni przed obniżką wynosiła 35,19 zł brutto -
Konfetti i Dym w Niebieskim na Ujawnienie Płci Zestaw 4 Sztuk
119,99 zł -10%107,99 złNajniższa cena tego produktu w ciągu ostatnich 30 dni przed obniżką wynosiła 105,59 zł brutto -
Zestaw do Pieczenia Chleba 2 szt Silikonowe Foremki Przybory Akcesoria
169,99 zł -10%152,99 złCena nie uległa zmianie -
Samoprzylepna Tapeta Szara Gruba 40 cm x 1000 cm Naklejki na Meble i Ściany
99,99 zł -10%89,99 złCena nie uległa zmianie -
Męskie Spodnie Jeansowe Proste Regular Fit Sprane Modne Czarne Rozmiar 32
119,99 zł -10%107,99 złCena nie uległa zmianie